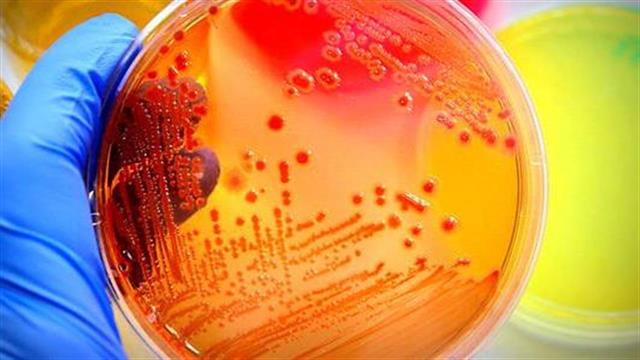
Τα ανθεκτικά μικρόβια πλήττουν Ελλάδα και Ιταλία

Το Ευρωπαϊκό Κέντρο Πρόληψης και Ελέγχου Νόσων (ECDC) διαπίστωσε ότι τα μικρόβια που είναι ανθεκτικά στα φάρμακα προκαλούν 33.000 θανάτους κάθε χρόνο σε όλη την Ευρώπη.
Το βάρος των λοιμώξεων που προκαλούν αυτά τα μικρόβια λέγεται ότι είναι συγκρίσιμο με αυτό της γρίπης, της φυματίωσης και του HIV μαζί.
Σύμφωνα με την ανάλυση του ECDC, η ανθεκτικότητά τους έχει αυξηθεί από το 2007. Η επιβάρυνση βρέθηκε να είναι η υψηλότερη στα βρέφη, ακολουθούμενη από άτομα ηλικίας 65 ετών και άνω, με την Ιταλία και την Ελλάδα να αντιμετωπίζουν το μεγαλύτερο πρόβλημα.
Σύμφωνα με δηλώσεις παραγόντων του ευρωπαϊκού οργάνου "Οι στρατηγικές για την πρόληψη και τον έλεγχο των ανθεκτικών στα αντιβιοτικά βακτηρίων απαιτούν συντονισμό σε ευρωπαϊκό και σε παγκόσμιο επίπεδο, καθώς και παρεμβάσεις προσαρμοσμένες στις εθνικές και τις τοπικές προκλήσεις".
Η ανάλυση μέτρησε την επιβάρυνση της υγείας από πέντε τύπους λοίμωξης που προκαλούνται από ανθεκτικά στα αντιβιοτικά βακτηρίδια, χρησιμοποιώντας τα δεδομένα του Ευρωπαϊκού Δικτύου Επιτήρησης της Αντιμικροβιακής Αντίστασης (EARS-Net) 2015.
Από τις συνολικές περιπτώσεις λοιμώξεων, το 63,5% αφορούσε την υγειονομική περίθαλψη, συμπεριλαμβανομένων των νοσοκομείων.
Ειδήσεις υγείας σήμερα
Σημάδια ότι σας λείπει πρωτεΐνη
HOPEgenesis: Αποστολές ζωής... για το θαύμα της ζωής
Ανοσολογία: Το Νόμπελ Ιατρικής 2025 και η έρευνα για τη θεραπεία αυτοάνοσων νοσημάτων
HOPEgenesis: Αποστολές ζωής... για το θαύμα της ζωής
HOPEgenesis: Αποστολές ζωής... για το θαύμα της ζωής Προκήρυξη 1.131 θέσεων ειδικευμένων ιατρών ΕΣΥ επί θητεία σε δημόσιες δομές
Προκήρυξη 1.131 θέσεων ειδικευμένων ιατρών ΕΣΥ επί θητεία σε δημόσιες δομές Ο Ε.Ε.Σ. τιμά την Παγκόσμια Ημέρα Ερυθρού Σταυρού & Ερυθράς Ημισελήνου
Ο Ε.Ε.Σ. τιμά την Παγκόσμια Ημέρα Ερυθρού Σταυρού & Ερυθράς Ημισελήνου Επίσκεψη Γεωργιάδη σε ιδιωτικό φαρμακείο για τη διάθεση ΦΥΚ σε δικαιούχο ασθενή
Επίσκεψη Γεωργιάδη σε ιδιωτικό φαρμακείο για τη διάθεση ΦΥΚ σε δικαιούχο ασθενή ΙΝΕΠΥ: Διεπιστημονικός διάλογος στο 8ο Πανελλήνιο Συνέδριο Νοσηλευτικών Ερευνών
ΙΝΕΠΥ: Διεπιστημονικός διάλογος στο 8ο Πανελλήνιο Συνέδριο Νοσηλευτικών Ερευνών ΕΟΔΥ: Ανάπτυξη σύγχρονου Ψηφιακού Μηχανισμού Επιδημιολογικής Επιτήρησης
ΕΟΔΥ: Ανάπτυξη σύγχρονου Ψηφιακού Μηχανισμού Επιδημιολογικής Επιτήρησης Σημάδια ότι σας λείπει πρωτεΐνη
Σημάδια ότι σας λείπει πρωτεΐνη Ανοσολογία: Το Νόμπελ Ιατρικής 2025 και η έρευνα για τη θεραπεία αυτοάνοσων νοσημάτων
Ανοσολογία: Το Νόμπελ Ιατρικής 2025 και η έρευνα για τη θεραπεία αυτοάνοσων νοσημάτων Μπορεί να μικρύνει το πέος μου;
Μπορεί να μικρύνει το πέος μου; Πώς προχωρά η συγκεντροποίηση της αιμοδοσίας-Ποια νοσοκομεία έχουν συνδεθεί με το ΕΚΕΑ
Πώς προχωρά η συγκεντροποίηση της αιμοδοσίας-Ποια νοσοκομεία έχουν συνδεθεί με το ΕΚΕΑ Νοσοκομείο Καβάλας: Το θερμό επεισόδιο του διοικητή με δύο γιατρούς και οι συλλήψεις
Νοσοκομείο Καβάλας: Το θερμό επεισόδιο του διοικητή με δύο γιατρούς και οι συλλήψεις Οι χειρότερες τροφές για πριν τον ύπνο
Οι χειρότερες τροφές για πριν τον ύπνο Οι δύσκολες ιατρικές αποφάσεις στο τέλος της ζωής - Παίζει ρόλο η ηλικία του ασθενή;
Οι δύσκολες ιατρικές αποφάσεις στο τέλος της ζωής - Παίζει ρόλο η ηλικία του ασθενή; Επικροτούν οι παθολόγοι την εξαίρεση του προσωπικού γιατρού από επισκέψεις κατ΄ οίκον
Επικροτούν οι παθολόγοι την εξαίρεση του προσωπικού γιατρού από επισκέψεις κατ΄ οίκον Aποσύρσεις φαρμάκων και αποχωρήσεις στελεχών
Aποσύρσεις φαρμάκων και αποχωρήσεις στελεχών Καθηγητής Τσακρής: Πόσο επικίνδυνος είναι ο χανταϊός
Καθηγητής Τσακρής: Πόσο επικίνδυνος είναι ο χανταϊός Πότε και πώς πρέπει να δηλώνονται ανεπιθύμητα συμβάντα σε ασθενείς
Πότε και πώς πρέπει να δηλώνονται ανεπιθύμητα συμβάντα σε ασθενείς